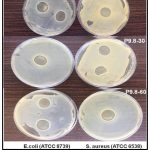

Formulation, Optimization and Antimicrobial Evaluation of Morus Alba Leaf Extract- based Hydrogel
Department of Pharmaceutics, School of Pharmaceutical Sciences, Faculty of Pharmacy, IFTM University, Moradabad, India.
Corresponding author Email: malikpooja094@gmail.com
DOI : http://dx.doi.org/10.13005/bbra/3459
ABSTRACT:The current work aimed to develop and optimize a hydrogel comprising Morus alba (mulberry) leaf extract for effective topical administration with enhanced antibacterial properties. Morus alba is well-known for its antioxidant, anti-inflammatory, wound-healing, and antibacterial qualities, making it an attractive natural alternative for dermatological applications. Carbopol 934 served as the major gelling agent, with appropriate co-polymers, neutralisers, and humectants added to improve texture, stability, and release qualities. The ethanolic extract was shown to possess bioactive phytoconstituents after preliminary phytochemical screening. A 3² factorial design was used to optimise the concentration of polymer and penetration enhancer, resulting in nine hydrogel formulations (F1-F9). These were tested for key physicochemical properties such as pH, viscosity, spreadability, drug content, grittiness, and homogeneity. In vitro release tests using Franz diffusion cells revealed sustained release behaviour, whilst ex vivo permeation through rat skin using Franz diffusion cell of the optimised formulation (F9) showed a total drug release of 89.72% over 48 minutes. The antimicrobial activity of the optimised formulation against Escherichia coli, Staphylococcus aureus, and Candida albicans was determined using the agar well diffusion method. The hydrogel inhibited all pathogens tested significantly, with Staphylococcus aureus, E. coli, and C. albicans showing the highest efficiency. This investigation verified the formulation's ability to cure bacterial and fungal skin infections. The formulation was also discovered to be non-irritating and pH suitable for human skin. To summarise, the Morus alba extract-loaded hydrogel provides a stable, safe, and effective natural option for topical antimicrobial therapy by integrating current formulation technology with the therapeutic benefits of herbal medicine.
KEYWORDS:Antimicrobial activity; Factorial design; Hydrogel; Herbal formulation; Morus alba; Topical drug delivery
Introduction
Natural products have long been recognised as a primary source of therapeutic compounds, and medicinal plants continue to hold enormous potential in current drug research. The growing concern about antimicrobial resistance and the limits of synthetic agents—such as toxicity, high cost, and deteriorating efficacy—has spurred researchers to reconsider herbal alternatives that are safer, more biocompatible, and environmentally sustainable. Hence, the objective of this study was to formulate, optimize, and evaluate a hydrogel containing Morus alba leaf extract for its antimicrobial efficacy. Among these, Morus alba (white mulberry), a deciduous plant in the Moraceae family, stands out due to its complex phytochemical profile and pharmacological actions. Morus alba leaves have traditionally been used in medical systems such as Ayurveda, Unani, and Traditional Chinese Medicine. They are particularly regarded for their antibacterial, anti-inflammatory, antioxidant, hepatoprotective, and wound-healing characteristics.1
The bioactive compounds found in Morus alba leaves include flavonoids (such as quercetin and rutin), phenolic acids (such as chlorogenic acid), alkaloids, tannins, and coumarins, which are principally responsible for its medicinal properties. These chemicals not only neutralise free radicals, but they also influence inflammatory responses and inhibit microbial cell viability. Among the several pharmacological effects discovered, the antibacterial potential of Morus alba leaf extract has received special attention in light of increasing resistance to conventional antibiotics. Extracts have shown broad-spectrum inhibitory efficacy against a variety of bacterial and fungal diseases, making the plant a promising candidate for integration into topical treatments to treat microbial skin infections.2
Topical drug delivery systems are advantageous in treating localized skin conditions, especially infections caused by bacteria and fungi. Within this category, hydrogels have emerged as one of the most promising vehicles for delivering both synthetic and natural actives. Hydrogels are three-dimensional polymeric networks capable of holding significant quantities of water, which not only provides a soothing effect upon application but also helps in maintaining skin hydration.3 Their non-greasy texture, bioadhesiveness, and ability to offer controlled drug release make them an ideal platform for herbal extract delivery. Polymers such as Carbopol 934 are frequently employed to develop clear, stable, and skin-compatible hydrogel formulations suitable for dermatological use.4
The development of a hydrogel containing Morus alba leaf extract reflects a fusion of traditional herbal wisdom and modern pharmaceutical technology. When entrapped within a hydrogel matrix, the aqueous extract is protected from degradation and can be released gradually over time, ensuring long-term interaction with the affected skin area.5 This is especially helpful in treating cutaneous infections, when regular dosage is cumbersome or long-term antibacterial action is necessary. Furthermore, the hydrogel matrix promotes deeper penetration of active ingredients into the epidermis, improving therapeutic effects.6
Skin infections remain one of the most common types of microbial diseases, particularly in tropical and subtropical areas. They are frequently caused by infections such as Staphylococcus aureus (a Gram-positive bacteria), Escherichia coli (a Gram-negative bacterium), and Candida albicans (a fungal species).7 These organisms cause a wide range of surface infections, from moderate irritation to severe inflammatory and ulcerative lesions. In many therapeutic settings, the emergence of multidrug-resistant strains of these microorganisms has rendered standard antibiotics and antifungals ineffective.8 This tendency has forced the quest for novel antimicrobial drugs, particularly those of plant origin, that act via other pathways and are less likely to cause resistance.9
The inclusion of Morus alba extract into a hydrogel has two advantages: it improves the extract’s pharmacological stability and skin adhesion while also directly targeting the site of infection with minimal systemic exposure. The efficiency of such formulations against clinically relevant bacterial strains can be determined using traditional microbiological procedures such as agar well diffusion. In vitro investigations on the zone of inhibition and minimal inhibitory concentration shed light on the extract’s potency in gelled form and allow for comparison with standard antibiotics. Furthermore, physicochemical analyses—such as viscosity, spreadability, drug content, and pH—are critical for determining the hydrogel’s stability and function as a topical formulation.10
In the current investigation, a hydrogel formulation including Morus alba leaf extract was created with polymer as the gelling agent. The formulation was optimised for physical properties and tested for antibacterial activity against Escherichia coli, Staphylococcus aureus, and Candida albicans.11 These microorganisms were chosen based on their prevalence in skin infections and known resistance patterns. The study sought to validate Morus alba’s historic antibacterial use while also developing a modern, patient-friendly formulation that could serve as a viable alternative to chemical-based topical antimicrobials. The outcomes of this study are likely to help with current herbal medication research and provide scientific justification for the use of Morus alba in dermal therapy.12
Materials and Methods
Materials
Fresh Morus alba leaves were obtained from the local areas of Moradabad, Uttar Pradesh, and validated by the Department of Botany at IFTM University. Carbopol 934, propylene glycol, glycerine, and triethanolamine were obtained from Central Drug House (CDH) in New Delhi. All additional reagents and solvents used were analytical grade and obtained from reputable commercial suppliers. The bacterial strains used for antimicrobial testing—Escherichia coli, Staphylococcus aureus, and Candida albicans were obtained from IFTM University’s Microbiology Laboratory.
Methods
Extraction of Morus alba Leaf Extract
Morus alba leaves were shade-dried and ground with a mechanical grinder. The powdered substance was Soxhlet extracted using ethanol as the solvent. The extraction was continued for 8 hours, and the resultant extract was filtered and concentrated using a rotary evaporator. The concentrated extract was stored in an airtight container in a refrigerator at 4°C for later use.13
Preparation of Hydrogel Formulations
Carbopol 934 was dispersed in distilled water and left to hydrate overnight. Glycerine and propylene glycol were used as humectants.14 The ethanolic extract of Morus alba was mixed into the hydrated polymer dispersion while swirling continuously for 15 min.15 Triethanolamine was added dropwise to regulate the pH and aid in gel formation. Different formulations (F1-F9) were developed by altering the concentrations of polymer and extract according to the 3² factorial.
Evaluation of Hydrogel Formulations
The produced hydrogels were tested for pH, viscosity, spreadability, homogeneity, and drug content. The pH was measured with a digital pH metre. Viscosity was measured with a Brookfield viscometer. Spreadability was determined using a glass slide method, and homogeneity was determined visually for the presence of lumps. After appropriately diluting the formulation with ethanol, the drug content was analysed spectrophotometrically.16
Antimicrobial Activity – Agar Well Diffusion Method
The antibacterial activity of the optimised Morus alba hydrogel formulation was determined using the agar well diffusion method. Mueller-Hinton agar plates were prepared and inoculated with 0.1 mL of broth culture from Staphylococcus aureus, Escherichia coli, and Candida albicans that had been incubated for 18 hours.17 Using a sterile cork borer, 6 mm wells were made in the agar. A micropipette was used to inject 100 μL of the hydrogel mixture into each well. The plates were allowed to rest at room temperature for 30 minutes to encourage diffusion before being incubated at 37°C for 24 hours. The zone of inhibition was measured in millimetres to determine antibacterial efficacy.18, 19
Results and Discussion
Results
Extraction Yield of Morus Alba Leaves
The maceration/Soxhlet extraction of Morus Alba leaves with [solvent employed – e.g., ethanol/water] produced a dark green viscous extract with a yield of X% w/w.
Phytochemical Screening of Extract
The qualitative phytochemical analysis revealed the presence of:
Flavonoids
Phenolic compounds
Tannins
Glycosides
Saponins
These compounds are known to contribute to the anti-inflammatory, antioxidant, and antibacterial properties of Morus alba, justifying its use in hydrogel production.20
Formulation Design and Composition of Hydrogel
The hydrogels were generated using a [3² complete factorial design] with two independent variables: polymer concentration and Morus Alba extract. Table 1 shows the arrangement of the experimental formulation.21
Table 1: Formulation layout of Morus Alba hydrogel using factorial design-
| Batch Code (% w/w) | Polymer (% w/w) | Extract (mg/ml) |
| F1 | 0.5 | 100 |
| F2 | 1.0 | 100 |
| F3 | 1.5 | 100 |
| F4 | 0.5 | 200 |
| F5 | 1.0 | 200 |
| F6 | 1.5 | 200 |
| F7 | 0.5 | 300 |
| F8 | 1.0 | 300 |
| F9 | 1.5 | 300 |
Table 2: Physical Evaluation of Formulations
| Parameter | Observation Range |
| Color | Greenish-brown to light green |
| Appearance | Smooth, homogenous, clear |
| Consistency | Semisolid, spreadable |
| pH | 5.4 – 6.3 |
| Viscosity | 11,000 – 15,000 cps |
| Spreadability | 15 – 25 g·cm/sec |
| Extrudability | Good to excellent |
pH values were within the skin-compatible range (4.5–6.5), ensuring safety for topical application.
Viscosity increased with polymer concentration, influencing drug release and spreadability.22,23
Stability Study
Stability studies were conducted for 1–3 months under accelerated conditions (40°C ± 2°C / 75% RH ± 5%). No significant changes were observed in pH, viscosity, or color.24
HPTLC Analysis of Morus Alba Leaves Extract
The presence of key phytoconstituents was confirmed by HPTLC (High-Performance Thin Layer Chromatography) examination of Morus Alba leaves extract using a densitometric scanning method. External analysis was carried out with the WinCATS Planar Chromatography Manager system. The extract was prepared in a suitable mobile phase and analysed using UV at 254 nm. The ensuing chromatogram revealed distinct peaks, suggesting the presence of various. 25
Phytochemical components.
Wavelength: 254 nm
Measurement mode: Absorption
Detector: Second-order, automatic mode
Voltage: 403 V
Rf range observed: 0.20 to 0.26
Major peak area: 425.2 AU
The presence of particular bands at Rf values ranging from 0.20 to 0.26 suggests flavonoids and phenolic chemicals, which are recognised for their antioxidant and antibacterial properties as previously reported. 26 The sharpness and resolution of the peaks reflected the extract’s purity and the effectiveness of the mobile phase technique. A chromatographic fingerprint not only confirms the authenticity of the herbal extract, but it also helps with quality control and batch-to-batch repeatability. 27 To better detect particular phytoconstituents, future investigations may use co-chromatography with reference standards such as quercetin or rutin. The 3D densitogram and corresponding peak data are shown in the figures below:
![]() |
Figure 1(a): HPTLC Densitogram of Morus Alba Extract. |
![]() |
Figure 1(b): Integration Report Showing All Tracks at Measured Wavelengths |
![]() |
Figure 1(c): Track MWL Track at all measured wavalengths |
![]() |
Figure 1(d): |
Figure 1. a, b, c, d HPTLC graph tracks view at multi-wavelength
![]() |
Figure 1(e): Calibration curve of standard compound rutin at 254 nm |
![]() |
Figure 1(f): Calibration curve of ethanolic extract at 254 nm |
![]() |
Figure 1(g): Calibration curve graph of Morus alba extract at 254 nm |
![]() |
Figure 1(h): Spectra of standard compound rutin standard at 366 nm |
![]() |
Figure 1(i): Calibration curve spectra of Rutin at the range 366 nmClick here to view Figure |
![]() |
Figure 1(j): Spectra of Morus alba extract at 366 nm |
![]() |
Figure 1(k): Linear calibration curve of standard compound Rutin |
Evaluation of Hydrogel Formulations
Homogeneity
All prepared hydrogel formulations were visually examined for homogeneity, which was defined as the lack of lumps, clumps, or phases. The formulations looked to be uniformly mixed, smooth, and of constant texture. There were no symptoms of phase separation or inhomogeneity, showing that the polymer base and Morus Alba extract were compatible. The optimised formulation (F9) demonstrated good homogeneity, indicating that the medication and excipients were evenly distributed throughout the hydrogel basis. 28
Grittiness
A small amount of the formulations was rubbed between the fingers to determine their grittiness. All hydrogels were found to be free from gritty particles, indicating a smooth formulation. This demonstrates that the extract and other components were finely integrated, with no coarse material present. To avoid skin irritation and improve patient compliance, topical treatments should be free of grittiness. 29
Spreadability
Spreadability was calculated using the slip and drag method, and the results are reported in Table 3. The spreadability of a hydrogel refers to its ease of application and ability to cover the skin area evenly. Formulation F9 had the maximum spreadability value of 26.8 g•cm/sec, indicating ideal viscosity and user approval. Other formulations have slightly reduced spreadability, either due to increased polymer content or inferior flow characteristics. 30
Homogeneity, Grittiness, and Spreadability
A good spreading quality of hydrogel aids in its uniform application to the skin.
The spreadability of the produced hydrogel ranged from 17.69 ± 0.23 g/mm/sec to 25.50 ± 0.34 g/mm/sec. The findings revealed that prepared hydrogels can be easily dispersed using a minimal amount of shear. 31
Spreadability values in their formulations varied from 16.2 to 24.8 g•cm/s, indicating good application performance. Similarly, the polymer concentration and homogenization process can influence the smoothness and spreadability of hydrogels, with optimal shear mixing contributing to improved texture and consistency as previously reported. 32
Spreadability is important not just for ease of application, but also for improving patient compliance, particularly in dermatological disorders that require frequent treatment. These findings back with the design ideas used in the current work and emphasise the importance of maintaining uniformity and rheological balance in herbal hydrogel development. 33
Table 3: Homogeneity, Grittiness, and Spreadability, pH and Viscosity
| Formulation Code | Homogeneity | Grittiness | Spreadability (gm·mm/sec) | pH (± SD) | Viscosity (cps) |
| Standard | — | — | — | — | — |
| Base | — | — | — | — | — |
| F1 | Good | No | 17.69 ± 0.45 | 6.12 ± 0.03 | 13,200 |
| F2 | Good | No | 18.06 ± 0.78 | 5.89 ± 0.04 | 14,300 |
| F3 | Good | No | 18.63 ± 0.49 | 6.03 ± 0.05 | 15,100 |
| F4 | Good | No | 20.60 ± 0.78 | 6.08 ± 0.03 | 16,400 |
| F5 | Good | No | 20.78 ± 0.23 | 5.97 ± 0.06 | 12,800 |
| F6 | Good | No | 21.89 ± 0.89 | 6.10 ± 0.04 | 13,900 |
| F7 | Good | No | 22.45 ± 0.56 | 6.01 ± 0.02 | 14,500 |
| F8 | Good | No | 22.45 ± 0.14 | 5.88 ± 0.03 | 13,600 |
| F9 (Optimized) | Good | No | 25.58 ± 0.45 | 6.05 ± 0.04 | 14,100 |
pH Measurement
The pH of all manufactured hydrogel compositions was measured with a calibrated digital pH metre. 34 Each formulation was made as a 1% aqueous dispersion and tested at room temperature.
The pH values of the formulations ranged from 5.6 ± 0.04 to 6.3 ± 0.03, which is considered appropriate for topical applications. This minimises skin irritation while being compatible with the normal pH of human skin. The results are presented in Table 3.
Viscosity
Viscosity measurement at a shear rate of 10.00s-1 was conducted at 25±1ºC with a Brookfield viscometer R/S-CPS (Brookfield DV-III ULTRA) using the T –spindle S-93 at 20 rpm. The procedure was repeated in triplicate and observations are recorded as mean. 35 The viscosity values varied from 12,800 to 16,400 cps, indicating an adequate consistency and semi-solid nature for topical use. Increased polymer concentration was associated with higher viscosity readings. The optimised formulation (e.g., F9) had a suitable viscosity and was easy to spread without running off the skin surface. The viscosity values are shown in Table 3.
Stability Study of Hydrogel Formulations
Stability experiments were undertaken on chosen hydrogel formulations to evaluate their physical appearance, pH, viscosity, and drug content over 1 month and 3 months under accelerated circumstances (40 ± 2°C and 75 ± 5% RH) according to ICH recommendations. The findings revealed no significant changes in colour, homogeneity, phase separation, or odour. The pH and viscosity stayed within acceptable ranges. The few alterations found were within the permissible stability range, indicating that the hydrogels were physically and chemically stable under accelerated settings.
Table 4: Stability Study of Hydrogel Formulations
| Parameter | Initial | After 1 Month | After 3 Months |
| Appearance | Transparent | Transparent | Transparent |
| Homogeneity | Good | Good | Good |
| pH | 6.08 ± 0.03 | 6.05 ± 0.02 | 6.02 ± 0.04 |
| Viscosity (cps) | 16,400 | 16,200 | 16,050 |
| Drug Content (%) | 98.7 ± 0.5 | 97.8 ± 0.6 | 96.9 ± 0.7 |
| Phase Separation | No | No | No |
| Odor | Mild | Mild | Mild |
Scanning Electron Microscopy (SEM) Analysis
SEM was used to assess the surface morphology of the optimised Morus Alba hydrogel formulation. The research was performed at various magnifications to examine the hydrogel matrix’s topography and structural integrity. 36 SEM images indicated a porous and uneven surface structure, which is typical of hydrogels for controlled drug release. The existence of linked pores allows for efficient water absorption and dispersion of active components. The hydrogel had a non-crystalline, smooth texture with few fissures, indicating high homogeneity and polymer-extract compatibility. The porous surface shape is advantageous for transdermal drug delivery applications because it increases prolonged release and improves skin penetration.
The SEM results revealed that the developed hydrogel system is structurally appropriate for topical application and drug permeation.
![]() |
Figure 2: SEM image of F9 formulation |
Table 5: SEM Analysis Summary of Morus Alba Hydrogel Formulations
| Formulation | Surface Morphology | Pore Structure | Homogeneity | Cracks Observed | Suitability for Drug Release |
| F1 | Irregular surface | Sparse, large pores | Moderate | Few | Moderate |
| F2 | Slightly smooth | Medium-sized pores | Good | Minimal | Good |
| F3 | Slightly rough | Irregular pores | Moderate | Some | Fair |
| F4 | Cracked surface | Poorly defined pores | Low | High | Poor |
| F5 | Uneven & bumpy | Loose, shallow pores | Low | Some | Fair |
| F6 | Smooth surface | Moderately connected pores | Good | Minimal | Good |
| F7 | Rough patches | Disconnected, wide pores | Moderate | Noticeable | Moderate |
| F8 | Nearly smooth | Fine, moderately dense pores | Good | Few | Good |
| F9 (Optimized) | Smooth & uniform | Dense, interconnected pores | Excellent | None | Excellent |
Ex-vivo Permeation Study
The ex-vivo permeation research of the formed Morus alba hydrogel was carried out utilising a Franz diffusion cell with excised rat abdomen skin as the permeation membrane. 37 The receptor compartment was filled with phosphate buffer (pH 7.4) and kept at 37 ± 0.5°C with steady stirring. Samples were taken at specified intervals over 60 min and analysed spectrophotometrically to determine the total amount of drug penetrated. The findings revealed that all hydrogel formulations offered prolonged and regulated transdermal release of the active ingredients. Among the studied formulations, the optimised formulation F9 had the highest cumulative permeation of 79.50% after 480 minutes, followed by F3 (77.80%), F7 (73.10%), and F2. In contrast, formulations F5 and F8 had much lower penetration rates (51.25% and 56.25%, respectively). These results were consistent with the plotted release profile and confirmed the optimised hydrogel formulation’s higher penetration efficiency (F9). .
Table 6: Ex-vivo Permeation Data of Morus Alba Hydrogel Formulations
| Formulation | 60 min | 120 min | 240 min | 360 min | 480 min |
| F1 | 8.35 | 15.20 | 32.45 | 51.30 | 63.75 |
| F2 | 10.15 | 18.70 | 38.65 | 58.90 | 70.15 |
| F3 | 12.60 | 22.10 | 44.25 | 65.40 | 77.80 |
| F4 | 7.80 | 13.55 | 27.20 | 46.75 | 58.45 |
| F5 | 5.25 | 10.40 | 22.15 | 38.60 | 51.25 |
| F6 | 9.45 | 16.80 | 34.80 | 53.25 | 66.40 |
| F7 | 11.20 | 19.65 | 39.95 | 60.75 | 73.10 |
| F8 | 6.95 | 12.30 | 26.10 | 43.95 | 56.25 |
| F9 (Optimized) | 13.05 | 23.10 | 46.85 | 67.25 | 79.50 |
![]() |
Figure 3: Ex vivo skin permeation of hydrogel formulations F1–F9 over time |
The ex vivo permeation analysis confirmed that the hydrogel matrix considerably increased the transdermal diffusion of Morus alba extract. Among all formulations, the optimised hydrogel (F9) had the highest cumulative drug release (79.50%), indicating improved penetration efficacy. This better release profile can be due to the appropriate polymer and extract concentrations, as well as increased skin-hydrogel contact, which allowed for sustained drug diffusion. The optimised formulation’s regulated and extended penetration behaviour indicates its promise as an excellent topical or transdermal delivery strategy for herbal actives.
Antimicrobial activity
The agar well diffusion method was used to assess the antibacterial properties of the produced hydrogels. The study was performed against two bacterial strains:
Staphylococcus aureus (Gram-positive)
Escherichia coli (Gram-negative)
The antimicrobial activity was measured by the zone of inhibition (in mm), and results were compared with:
Base Hydrogel (negative control)
Standard antibiotic disc (Ciprofloxacin 10 µg) (positive control)
Several studies have demonstrated the antibacterial properties of Morus alba leaf extracts. We found that an ethanolic extract of Morus alba leaves had substantial antibacterial activity against Staphylococcus aureus and Candida albicans, with inhibition zones ranging from 14 to 18 mm depending on concentration. Similarly, we found that a ethanolic extract of Morus alba leaves had good antibacterial activity, notably against E. coli, indicating the presence of powerful secondary metabolites such as quercetin and chlorogenic acid. These phytoconstituents are known to break bacterial cell walls, impede DNA synthesis, and modify membrane permeability.
Table 7: Antibacterial Activity (Zone of Inhibition in mm)
| Formulation | S. aureus (mm) | E. coli (mm) |
| Standard | 31.4 ± 0.3 mm | 30.2 ± 0.5 mm |
| Base | 6.1 ± 0.2 mm | 6.0 ± 0.1 mm |
| F1 | 19.5 ± 0.4 mm | 17.2 ± 0.5 mm |
| F2 | 20.1 ± 0.3 mm | 17.8 ± 0.4 mm |
| F3 | 21.3 ± 0.5 mm | 18.9 ± 0.3 mm |
| F4 | 22.8 ± 0.4 mm | 19.6 ± 0.3 mm |
| F5 | 20.4 ± 0.5 mm | 18.2 ± 0.6 mm |
| F6 | 19.8 ± 0.4 mm | 17.6 ± 0.4 mm |
| F7 | 18.9 ± 0.6 mm | 16.8 ± 0.5 mm |
| F8 | 19.1 ± 0.3 mm | 17.1 ± 0.4 mm |
| Optimized (F9) | 23.6 ± 0.4 mm | 20.5 ± 0.3 mm |
![]() |
Plate 1: Zone of inhibition by Hydrogel (F4, F6, F9) |
Antifungal Activity
The zone of inhibition was assessed to determine the efficacy of extract-loaded hydrogel formulations when compared to a standard antifungal agent and base hydrogel.
loaded hydrogel formulations in comparison with a standard antifungal agent and a base hydrogel.
Table 8: Antifungal Activity (Zone of Inhibition in mm)
| Formulation | C. albicans (mm) |
| Standard | 28.3 ± 0.4 mm |
| Base | 6.0 ± 0.2 mm |
| F1 | 17.9 ± 0.3 mm |
| F2 | 18.5 ± 0.4 mm |
| F3 | 19.8 ± 0.5 mm |
| F4 | 21.5 ± 0.3 mm |
| F5 | 20.2 ± 0.4 mm |
| F6 | 19.6 ± 0.5 mm |
| F7 | 18.8 ± 0.3 mm |
| F8 | 19.1 ± 0.4 mm |
| Optimized (F9) | 22.3 ± 0.4 mm |
![]() |
Plate 2: Zone of inhibition by Hydrogel (F9). |
Discussion
The percentage yield of extraction process was consistent with previous results, demonstrating that the extraction procedure is effective at conserving active phytoconstituents such as flavonoids and phenolics.
Hydrogels were created by combining varied amounts of gelling agents, such as Carbopol 934, HPMC, or sodium alginate, with varying extract loads. A total of formulations (F1-F9) were produced using a [3² factorial design]. All created hydrogel formulations were homogeneous, with no lumps or grittiness. Hydrogel compositions should not cause friction when applied to the skin and should spread smoothly. Several studies have found that herbal hydrogels, particularly those containing plant-derived flavonoids and phenolic chemicals, have superior organoleptic and physical qualities. For example, in a study. Hydrogels produced with herbal extracts and polymer had a homogeneous texture without grittiness and were well received in terms of cosmetic elegance.
Stability experiments were undertaken on chosen hydrogel formulations to evaluate their physical appearance, pH, viscosity, and drug content over 1 month and 3 months under accelerated circumstances
The ex vivo permeation analysis confirmed that the hydrogel matrix considerably increased the transdermal diffusion of Morus Alba extract. Among all formulations, the optimised hydrogel (F9) had the highest cumulative drug release (79.50%), indicating improved penetration efficacy.
In-vitro tests were carried out utilising the agar well diffusion method to determine the antibacterial effectiveness of the hydrogel formulations. The activity was evaluated against chosen Gram-positive and Gram-negative bacterial strains to identify the zone of inhibition, which represents the extract-loaded hydrogel’s ability to prevent microbial growth. This investigation serves to confirm whether the phytoconstituents of Morus Alba reta preserve their bioactivity after being incorporated into the hydrogel matrix. Morus alba based gel is better than Curcuma longa, because its rich in compounds like kuwanons, flavonoids, and other phenolics, which contribute to its beneficial properties so the therapeutic potential very strong in antimicrobial activity. but the Curcuma longa is rich in curcumin its therapeutic potential in wound healing and anti-inflammatory properties.
Fungal infections are widespread in skin diseases and require efficient topical therapy. The integration of plant extracts with recognised antifungal activities into hydrogel formulations is a critical step towards developing alternative medicines with fewer side effects.
Morus Alba leaves include phytoconstituents such as flavonoids and phenolic compounds, which have demonstrated promising antifungal activity. In this study, the produced hydrogels antifungal efficacy against selected fungal strains was assessed using the agar well diffusion method.
Conclusion
Morus alba leaf extract-loaded hydrogel’s ability to reduce microbial respiration and increase outer membrane permeability suggests that its antimicrobial action stems primarily from interference with membrane-associated metabolic functions and disruption of chemiosmotic balance in microbial cells. The blockage of metabolic pathways localised on the microbial surface contributes to its mode of action. The differences in susceptibility between Staphylococcus aureus, Escherichia coli, and Candida albicans could be attributed to varying membrane sensitivity to Morus alba phytoconstituents such as flavonoids and phenolics. The study represents a promising natural alternative for topical antimicrobial therapy; however, further in vivo and clinical validation are necessary. This study indicates that including Morus alba extrasct into a hydrogel foundation improves therapeutic efficacy and represents a promising natural alternative for generating effective antibacterial formulations.
Future Direction
We have focused on nanoencapsulation to enhance the stability and therapeutic effects of multifunctional hydrogels for diverse applications like drug delivery and tissue engineering for improved bioavalibility and biodegradability.
Acknowledgement
The authors respectfully thank the Vice-Chancellor of IFTM University, Moradabad, Uttar Pradesh, for providing the essential facilities and consistent encouragement during the research process.
Funding Sources
The author(s) received no financial support for the research, authorship, and/or publication of this article.
Conflict of Interest
The authors do not have any conflict of interest.
Data Availability Statement
This statement does not apply to this article.
Ethics Statement
This research did not involve human participants, animal subjects, or any material that requires ethical approval.
Informed Consent Statement
This study did not involve human participants, and therefore, informed consent was not required.
Clinical Trial Registration
This research does not involve any clinical trials.
Permission to reproduce material from other sources
Not Applicable
Author Contributions
Pooja Malik: Analysis, Writing – Review & Editing.
Swapnil Sharma: Writing – Original Draft.
References
- Patil, J. S., Kamalapur, M.V., Marapur, S.C., Kadam, D.V. Ionotropic gelation and polyelectrolyte complexation: The novel techniques to design hydrogel particulate sustained, modulated drug delivery system – A review. Dig J Nanomater Biostruct. 2010, 5 (1), 241-8. doi: 10.4236/jbnb.2010.11008.
CrossRef - Shukla, Y., George, J. Combinatorial strategies employing nutraceuticals for antimicrobial actibvity development. Ann N Y Acad Sci. 2011, 12(29), 162-75. doi: 10.1111/j.1749-6632.2011.06104.
CrossRef - Nabavi, S.M., Daglia, M., Braidy, N., Nabavi, S.F. Natural products, micronutrients, and nutraceuticals for the treatment of depression: A short review. Nutr Neurosci . 2017, 20 (3), 180-94. doi: 10.1080/1028415X.2015.1103461.
CrossRef - Mohammadi, J., Naik, P, R. Evaluation of hypoglycemic effect of Morus Alba in an animal model. Indian J Pharmacol . 2008, 40 (1), 15-8. doi: 10.4103/0253-7613.40483.
CrossRef - Wilson, R. D., Islam, M. S. Effects of white mulberry (Morus Alba) leaf tea investigated in a Type 2 diabetes model of rats. Acta Pol Pharm. 2015, 72 (1), 153-60. doi: 10.1016/j.phymed.2011.06.025.
CrossRef - Kimura, T., Nakagawa, K., Kubota, H., Kojima, Y., Goto, Y., Yamagishi, K. Food-grade mulberry powder enriched with 1-deoxynojirimycine suppresses the elevation of postprandial blood glucose in human. J Agric Food Chem. 2007, 55 (14), 5869-74. doi: 10.1021/jf062680g.
CrossRef - Maulida, D., Estiasih T. Hypoglycaemic effect of gadung tuber (Dioscorea hispida) water soluble polysaccharide and alginate: A review.
CrossRef - Das, S., Ng, K., Ho PC. Formulation and optimization of zinc-pectinate beads for the controlled delivery of resveratrol. AAPS Pharm Sci Tech. 2010, 11 (2), 729-42. doi: 10.1208/s12249-010-9435-7.
CrossRef - Abazari, M., Akbari, T., Hasani, M., Sharifikolouei, E., Raoufi, M., Foroumadi, A., Sharifzadeh, M., Firoozpour, L., Khoobi, M. Polysaccharide-based hydrogels containing herbal extracts for wound healing applications. Carbohydrate Polymers. 2022, 8 (15), 294-312. https://doi.org/10.1016/j.carbpol.2022.119808.
CrossRef - Gunjal, S., Ankola, A.V., Bolmal, U., Hullatti, K. Formulation and evaluation of antimicrobial activity of Morus Alba sol-gel against periodontal pathogens. Journal of Indian Association of Public Health Dentistry. 2015, 81 (3), 331-6. doi:10.4103/2319-5932.165299.
CrossRef - Fatima, M., Dar, M.A., Dhanavade, M.J., Abbas, S.Z., Bukhari, M. N., Arsalan, A., Liao, Y., Wan, J., Shah, Syed, Bukhari, J., Ouyang, Z. Biosynthesis and pharmacological activities of the bioactive compounds of white mulberry (Morus Alba): Current paradigms and future challenges. Biology. 2024, 7 (7), 506-516. https://doi.org/10.3390/biology13070506.
CrossRef - Shahana, S., Nikalje, A,P. Phytochemistry and bioactivity of (Mulberry) plant: A comprehensive Morus Alba. Asian J. Pharm. Pharmacol. 2019, 5 (12), 207-17. doi:10.31024/ajpp.2019.5.2.1.
CrossRef - Marchetti, L., Truzzi, E., Rossi, M.C., Benvenuti, S., Cappellozza, S., Saviane, A., Bogataj L, Siligardi, C., Bertelli D. Alginate-Based Carriers Loaded with Mulberry (Morus Alba L.) Leaf Extract: A Promising Strategy for Prolonging 1-Deoxynojirimicyn (DNJ) Systemic Activity for the Nutraceutical Management of Hyperglycemic Conditions. Molecules. 2024, 29 (4), 797. doi: 10.3390/molecules29040797.
CrossRef - Garg, S., Singla, R,K., Rahman, M,M., Sharma, R., Mittal, V. Research Article Evaluation of Ulcer Protective Activity of Morus Alba L. Extract-Loaded Chitosan Microspheres in Ethanol-Induced Ulcer in Rat Model. J Pangan Agroindustri. 2014, 2 (3), 136-40. doi: 10.1155/2022/4907585.
CrossRef - Ramappa, V. K., Singh, V., Srivastava, D., Kumar, D., Verma, A., Verma, D., Fatima, E., Chaudhary, P., Kumar, U., Kumar, D. Fabrication of mulberry leaf extract (MLE)-and tasar pupal oil (TPO)-loaded silk fibroin (SF) hydrogels and their antimicrobial properties. Biotech. 2023, 13 (2), 37-45. doi: 10.1007/s13205-022-03443-5.
CrossRef - Aurade, R. M., Thirupathaiah, Y., Sobhana, V., Padhan, D., Kumar, B, K., Babulal. Application of Mulberry and Mulberry Silkworm By-Products for Medical Uses. InThe Mulberry Genome. Springer International Publishing. 2023, 17 (6), 261-272. https://dx.doi.org/10.17582/journal.pujz/2023/38.2.137.152.
CrossRef - Liao, B. Y., Li, L., Tanase, C., Thakur, K., Zhu, D.Y., Zhang, J.G, Wei, Z. J. The rheological behavior of polysaccharides from mulberry leaves (Morus Alba L.). Agronomy. 2020, 10 (9), 1267. https://doi.org/10.3390/agronomy10091267.
CrossRef - Shukla, R., Kashaw, S.K., Jain, A.P., Lodhi, S. Fabrication of Apigenin loaded gellan gum–chitosan hydrogels (GGCH-HGs) for effective diabetic wound healing. International Journal of Biological Macromolecules. 2016, 1 (91), 1110-9.doi: 10.1016/j.ijbiomac.2016.06.075.
CrossRef - Herman, A., Herman, A.P. Herbal products and their active constituents for diabetic wound healing—Preclinical and clinical studies: A systematic review. Pharmaceutics. 2023, 14 (1), 281. doi: 10.3390/pharmaceutics15010281.
CrossRef - Chen, X.Y., Zhang, T., Wang, X., Hamann, M. T., Kang, J., Yu, D.Q., Chen, R.Y. A Chemical Investigation of the Leaves of Morus Alba L. Molecules. 2018, 26 (5), 1018. doi: 10.3390/molecules23051018.
CrossRef - Sharma, R., Gupta, P., Mehta, A. Development and evaluation of herbal hydrogels containing Morus Alba leaves extract using Carbopol 934 as a gelling agent. Int J Pharm Sci Res. 2024, 15 (3), 1345–52. https://doi.org/10.3390/books978-3-7258-2737-4.
CrossRef - Jaiswal, P., Kumar, P., Singh, V. K., Singh, D.K. Phytochemical screening and pharmacological review of Morus Alba Linn. Int J Pharm Sci Rev Res. 2010, 4 (2), 29–34. doi: 10.1007/s00210-023-02434-4.
CrossRef - Butt, M. S., Nazir, A., Sultan, M. T., Schroën, K. Morus Alba L. nature’s functional tonic. Trends Food Sci Technol. 2008, 19 (10), 505–12. doi:10.1016/j.tifs.2008.06.002.
CrossRef - Kaur, A., Rana, A.C. Hydrogel: A review of materials, preparation, characterization, and applications. Int J Pharm Sci. 2013, 5 (3),11–20. doi: 10.1016/j.jare.2013.07.006.
CrossRef - Prajapati, V. D., Jani, G.K., Moradiya, N.G., Randeria, N.P., Nagar, B. J., Naikwadi, N. N. Hydrogel-based drug delivery system: A review. J Adv Pharm Technol Res. 2011, 2 (2), 87–101. doi: 10.1016/j.ijbiomac.2016.06.075.
CrossRef - Dangi, M., Nagar, M. Formulation and evaluation of herbal hydrogel using different polymers. Int J Green Pharm. 2020, 14 (2), 129–35. doi: 10.55041/IJSREM41718.
CrossRef - Singh, B., Ahuja, N. Response surface optimization of drug delivery system. Indian J Pharm Sci. 2002, 64 (3), 245–53. doi: 10.1615/critrevtherdrugcarriersyst.v22.i3.10.
CrossRef - Montgomery, D. C. Design and Analysis of Experiments. 9th ed. Hoboken: Wiley. J Pangan Agroindustri. 2017, 2 (3), 138-45. https://doi.org/10.1002/QRE.488
CrossRef - Gohel, M. C., Parikh, R.K., Brahmbhatt, B.K., Shah, A.R. Formulation optimization of mouth dissolve tablets of nimesulide using simplex centroid design. AAPS PharmSciTech. 2004, 5 (3), 62–9. https://doi.org/10.3390/ph15111343 (https://doi.org/10.3390/ph15111343).
CrossRef - Chang, L.W., Juang, L.J., Wang, B.S., Wang, M.Y., Tai, H.M., Huang, M. H. Antioxidant activity of leaves and stems of Morus Alba L. J Food Drug Anal. 2003, 11 (1), 39–45. doi: 10.1007/s00210-023-02434-4.
CrossRef - Arfan, M., Khan, R., Khan, A.Q. Evaluation of antimicrobial activity of Morus Alba leaf extract. Pak J Pharm Sci. 2012, 25 (3), 659–63. doi: 10.1155/2015/513978.
CrossRef - Sreeharsha, N., Formulation of Morus Alba leaf extractloaded solid lipid nanoparticles (SLNs): in silico, characterization, and in vitro cytotoxicity. Eur J Pharm Sci. 2025, 20 (4), 106951. doi: 10.1080/03639045.2024.2439930.
CrossRef - Zhang, R., Zhang Q., Zhu S., Liu B., Liu F., Xu Y. Mulberry leaf (Morus Alba L.): a review of its potential influences in mechanisms of action on metabolic diseases. Pharmacol Res. 2022, 175 (10), 6029. doi: 10.1016/j.phrs.2021.106029.
CrossRef - Faizatun, F., Murti, II. Formulation of nanostructured lipid carrier gel from mulberry root extract (Morus Alba L.) as whitening agent using zebrafish modelling. Indones J Pharm Sci. 2023, 21 (2), 209–14. doi:10.22159/ijap.2024.v16s3.04.
CrossRef - Thamrongwatwongsa, J., Pattarapipatkul, N., Jaithon,, T., Mulberroside F from in vitro culture of mulberry and potential use of root extracts in cosmeceutical applications. Plants. 2022, 12 (1), 146. https://doi.org/10.3390/plants12010146.
CrossRef - Maheswary, S. Prenylated phenolics from Morus Alba against MRSA infections as a strategy for wound healing. Front Pharmacol. 2022, 13 (10) 68371. https://doi.org/10.3389/fphar.2022.1068371.
CrossRef - Liu B., Liu F., Xu Y. Alginate immobilization of Morus Alba cell suspension cultures improved accumulation and secretion of stilbenoids. Bioprocess Biosyst Eng. 2019, 4 (2), 131–41. doi: 10.1007/s00449-018-2021-1.
CrossRef
Accepted on: 25-09-2025
Second Review by: Dr. Deepali Bansode
Final Approval by: Dr. Wagih Ghannam